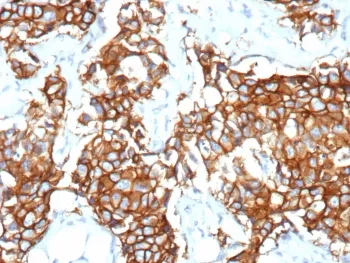
HER2 Recombinant Antibody / ErbB2 - image 1

HER2 Recombinant Antibody / ErbB2
CAT:
800-V5422-100UG
Size:
100 µg
Price:
Ask
- Availability: 24/48H Stock Items & 2 to 6 Weeks non Stock Items.
- Dry Ice Shipment: No

HER2 Recombinant Antibody / ErbB2
Description:
C-erbB-2/HER-2 is a member of the EGFR family. Receptors of this family are located on the plasma membrane and consist of an extracellular ligand-binding domain that is connected to a large intracellular domain by a single transmembrane sequence. c-erbB-2/HER-2 protein is over-expressed in a variety of carcinomas especially those of breast and ovary.UniProt:
P04626Host:
MouseImmunogen:
Recombinant protein corresponding to the cytoplasmic domain (within amino acids 955-1255) of human c-erbB2/HER-2 was used as the immunogen for the recombinant ErbB2 antibody.Clonality:
MonoclonalIsotype:
IgG2b κType:
RecombinantApplications:
IHC-PFormat:
PurifiedBuffer:
0.2 mg/ml in 1X PBS with 0.1 mg/ml BSA (US sourced), 0.05% sodium azideReconstitution:
Aliquot the recombinant ErbB2 antibody and store frozen at -20oC or colder. Avoid repeated freeze-thaw cycles.Limitations:
This recombinant ErbB2 antibody is available for research use only.CAS Number:
9000-83-3